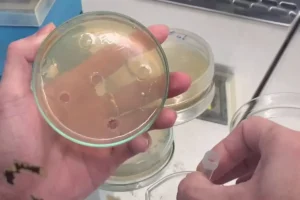

Lưu trữ Danh mục: Nhà Nông 24h – Tổng hợp tin tức, kỹ thuật
Xây dựng lực lượng Kiểm ngư chính quy, hiện đại
Thứ trưởng Bộ NN-PTNT Phùng Đức Tiến nhấn mạnh: ‘Tinh thần là phải xây dựng
Nuôi cá chình trong ao đất mang lại hiệu quả kinh tế cao
Tại Bình Định, cá chình chủ yếu phân bố trên đầm Trà Ổ, hầu hết
Ứng dụng IoT trong nuôi trồng thủy sản
Các nhà nghiên cứu tại Viện Công nghệ thông tin và Viện Hàn lâm Khoa
Xác định độ nhạy kháng sinh trong nuôi tôm thẻ chân trắng
Một số kháng sinh khác, thời gian gần đây được người nuôi tôm đưa vào
Thị trường thủy sản ‘bật tín hiệu xanh’
‘Từ giờ đến cuối năm, ngành thủy sản phải làm gì? Chiến lược chỉ là
Phương pháp đục lỗ đĩa thạch xác định độ nhạy kháng sinh trong nuôi tôm
Một số kháng sinh khác, thời gian gần đây được người nuôi tôm đưa vào
Đục lỗ đĩa thạch xác định độ nhạy kháng sinh dùng trong nuôi tôm
Một số kháng sinh khác, thời gian gần đây được người nuôi tôm đưa vào
Vi sinh có lợi dạng hiếu khí và yếm khí trong nuôi tôm thâm canh
Để giải quyết vấn đề chất lượng nước trong ao nuôi thâm canh, sử dụng
Sử dụng ong bắp cày thay thế cho bột cá trong thức ăn của cá rô phi
Trong ngành sản xuất loài cá này, thức ăn chiếm khoảng 80% chi phí. Do
Thiệt hại đến 500 triệu USD nếu thuỷ sản Việt Nam bị áp “thẻ đỏ”
Dự kiến vào tháng 10 năm 2023, Đoàn thanh tra của Ủy ban châu Âu
Nhân giống và nuôi mực thương phẩm thành công trong môi trường bán tự nhiên
NINH THUẬN Mô hình nhân giống và nuôi mực thương phẩm trong môi trường bán
Giá tôm chạm đáy – người nông dân đang chờ cứu?
Dịch bệnh xuất hiện nhiều, đẩy chi phí đầu vào lên cao nhưng giá bám